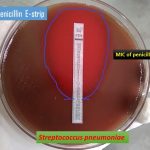
MIC of penicillin determination on Streptococcus pneumoniae
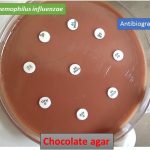
Haemophilus influenzae antibiotic sensitivity testing in chocolate agar

Collection Group: Clinical Bacteriology
MIC of polymyxin B and Colistin sulphate deternination on Pseudomonas aeruginosa
 MIC of polymyxin B and Colistin sulphate E-strips of polymyxin...
MIC of polymyxin B and Colistin sulphate E-strips of polymyxin...
MIC of Penicillin Determination for Streptococcus pneumoniae
MIC of Penicillin Penicillin E-strip uses to determine penicillin minimum...
MIC of Penicillin Penicillin E-strip uses to determine penicillin minimum...
Haemophilus influenzae: Antibiotics Sensitivity Testing (AST) in Chocolate Agar
Haemophilus influenzae AST in Chocolate agar The above image is...
Haemophilus influenzae AST in Chocolate agar The above image is...
